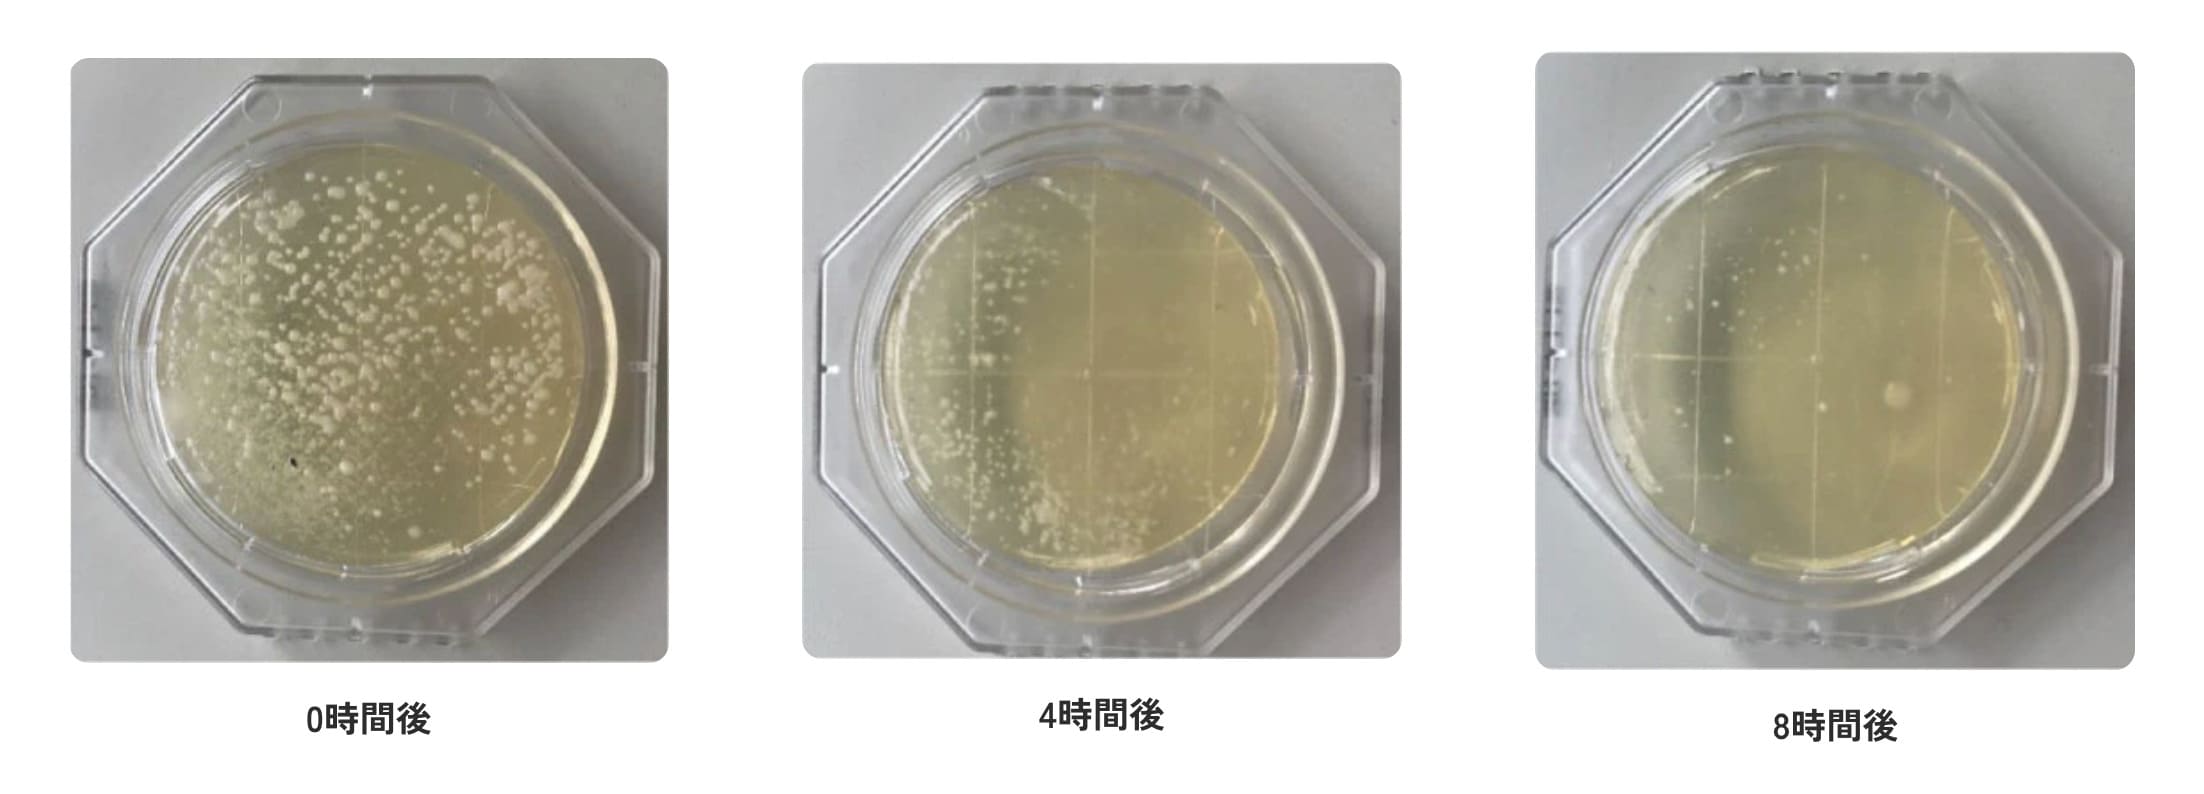

驚くほどの靴消臭
ROSY LILY 靴の消臭パウダー


家族の靴の“あの臭い”、今すぐ消したい方へ
部活帰りの靴、仕事終わりの革靴、蒸れたスニーカー──その悪臭、スプレーではもう効きません。
ROSY LILYの消臭パウダーなら
根本から消えて、半年間ずっと快適。
香りでごまかさず、長く続く清潔を。


ROSY LILYなら“菌ごと消せる”から、
ニオイの元が消える
菌の繁殖を抑え、靴の中を快適に保ちます。

靴の中は、汗や湿気で一年中ジメジメ。
温度30℃以上・湿度80%以上という、雑菌が増えやすい環境が整っています。
汗や皮脂をエサに雑菌が繁殖し、ニオイの元となる「イソ吉草酸」などを発生。
放っておくと、菌は靴内部にこびりつき、スプレーでは消せない慢性的な臭いになります。
一般的なスプレーは、ニオイに香りをかぶせて“ごまかす”だけ。
でもROSY LILYの消臭パウダーは違います。
臭いの原因となる「菌」や「アンモニア」に直接作用し、化学反応でニオイの元ごと取り除きます。
実験では、たった0.5gのパウダーでアンモニア・酢酸・イソ吉草酸の消臭率が86%以上を記録しました。
ほかの方法との違いを、わかりやすく比較しました。
消臭パウダーは化学的消臭で根本原因にアプローチするため、効き目こそ遅いものの、効果や持続時間が全く違います。
| 項目 | ROSY LILY | スプレー | 活性炭・重曹など |
|---|---|---|---|
| 即効性 | × 遅い | ○ 一時的 | × 遅い |
| 持続性 | ◎ 半年持続 | △ 数時間〜1日 | △ 効果が不安定 |
| 根本除去 | ◎ 菌を除菌 | × マスキング | △ 吸着のみ |
| 安全性 | ◎ 天然由来で安心 | △ 香料・アルコール | ○ |

ミョウバン・酸化亜鉛・銀など、医薬品や化粧品にも使われる安心素材です。
さらにロジーリリーの消臭パウダーには、3大消臭成分と銀イオン(Ag+)を独自バランスで配合しています。
この組み合わせにより、臭いの元から除去し、効果が長く続くㅤ
毎日使っても粉残りや香りが気にならず、お子様から大人まで、家族みんなでお使いいただけます


消臭スプレー、活性炭、重曹…靴のニオイ対策には、いろいろな方法があります。
でも、それで本当に「臭いが戻ってこない」実感、ありましたか?
ROSY LILYのパウダーは、香りでごまかすのではなく、
ニオイの原因菌そのものに作用して、根本から断つから違います。
一度のケアで、面倒な毎日からも解放されます。
ほかの方法との違いを、わかりやすく比較しました。
消臭パウダーは化学的消臭で根本原因にアプローチするため、効き目こそ遅いものの、効果や持続時間が全く違います。
STEP1
靴の中にパウダーを2〜3回振りかけます。
STEP2
全体にパウダーが行き渡るよう、靴を軽く振ってください。
STEP3
そのまま靴を履くだけで、消臭が始まります。

優質洗鞋泡
其他護理產品